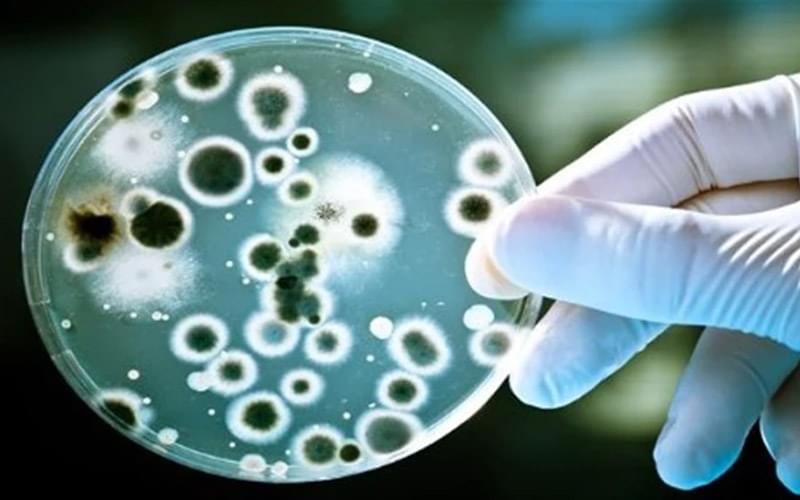
Preparos de Meios de Cultura e seus Controles de Qualidade

Treinamentos
- Home
- Laboratórios
- Preparos de Meios de Cultura e seus Controles de Qualidade
Cálculo de Incerteza Físico Química
2 de abril de 2023Elaboração e Interpretação de Cartas de Controle
2 de abril de 2023Preparos de Meios de Cultura e seus Controles de Qualidade
Datas:
-
Turma: A definir;
Carga horária: 8 horas
Horário: 18:30 às 22:30h
Tipo de Curso: Online Ao Vivo
Plataforma: Google Meet / Microsoft Teams
Instrutora: Flávia Isabel
Graduada em Engenharia de Alimentos pela Universidade Federal de Goiás (2003), especialização em Tecnologia e Qualidade de Alimentos de Origem Vegetal pela Universidade Federal de Lavras (2007), mestrado em Ciência e Tecnologia de Alimentos pela Universidade Federal de Goiás (2007) e MBA em Gestão de Pessoas por Competências, Indicadores e Coaching pelo IPOG (2019).
Tem experiência em microbiologia, tanto de alimentos quanto de cosméticos, onde atuou como analista, coordenadora, gestora de equipe. Possui conhecimento e experiência na ISO 17025.
Teve grande atuação na área de Educação, com ênfase em Ensino-Aprendizagem, atuando principalmente nos seguintes temas: Tecnologia e Microbiologia. Auditora de gestão e de ensaios microbiológicos.
Cronograma:
- Introdução
- Apresentação geral do curso e objetivos
- Revisão sobre microrganismos e meios de cultura
- Microrganismos e Curva de Crescimento Microbiano
- Fases de crescimento microbiano:
- Fatores que Influenciam o Crescimento Microbiano
- Fatores Físicos: Temperatura, pH, Pressão osmótica
- Fatores Químicos: Carbono, Nitrogênio, Enxofre, Fósforo, Oxigênio, Elementos traços
- Meios de Cultura e Sua Classificação
- Classificação quanto à consistência: Líquidos, Semissólidos, Sólidos
- Classificação quanto à função: Seletivos, Não Seletivos, Diferenciais
- Preparo de Meios de Cultura
- Etapas do preparo: Pesagem, Hidratação, Esterilização, Ajuste de pH, Distribuição
- Armazenamento e validade
- Controles de Qualidade Aplicados aos Meios de Cultura
- Avaliação visual
- Verificação de esterilidade
- Aferição de pH
- Verificação de desempenho (Seletividade, Especificidade, Produtividade)
- Testes adicionais: Antibióticos, Enzimas, Vitaminas, Glicerol, Emulsão de gema de ovo
- Verificação de Métodos e Incerteza de Medição
- Métodos de controle e validação
- Procedimentos para garantir confiabilidade dos ensaios
- Verificação de seletividade, especificidade e produtividade
- Cálculo de incerteza de medição
- Manuseio de Cepas e Boas Práticas Laboratoriais
- Cuidados no manuseio de microrganismos
- Boas práticas laboratoriais para evitar contaminações
Material fornecido:
- Material de apoio para o treinamento;
- Certificado de participação.
Informações sobre o Pagamento / Acesso ao Treinamento:
- Assim que o treinamento for confirmado, enviaremos a solicitação do pagamento (boleto, pix ou link para cartão de crédito), conforme opção escolhida pelo participante.
- Formas de Pagamento: No Cartão de Crédito (em até 6x) ou no Boleto/Pix com 5% de desconto.
- A confirmação do Treinamento é enviada em até 2 (dois) dias antes da data programada do treinamento.
- As informações de acesso e o material de apoio serão enviados ao e-mail cadastrado em até um dia antes do treinamento.
Produtos relacionados
-
Ferramentas Estatísticas Aplicadas a Laboratório
Datas:
-
Turma :5 a 8 de Maio;
-
-
Validação de Métodos Físico Químicos
Datas:
-
Turma: 8 a 9 de Abril;
-
Avaliações
Não há avaliações ainda.